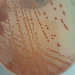
Nadia Safia

Erasmus students Logroño
-
 Viviana Molina Samayoa
Viviana Molina Samayoa
Born in Ensenada. Currently lives in Ensenada. Studied at Universidad Autónoma de Baja California. Has a scholarship Logroño 2018 / 2019 at university Universidad de La Rioja
-
 GoProGoMad Gian
GoProGoMad Gian
Born in Bassano Del Grappa. Currently lives in Trento. Studied at Università degli Studi di Trento. Has a scholarship Logroño 2018 / 2019 at university Universidad de La Rioja
-
 Rocio Echegaray
Rocio Echegaray
Born in Pamplona. Currently lives in Pamplona. Has a scholarship Logroño 2018 / 2019
-
 cynthia arguelles
cynthia arguelles
Has a scholarship Logroño 2018 / 2019 at university Universidad de La Rioja
-
 Anthonella Olivares
Anthonella Olivares
Born in Lima. Currently lives in Lima. Studied at Pontificia Universidad Católica del Perú. Has a scholarship Logroño 2018 / 2019 at university Universidad de La Rioja
-
 Natalia Mazurek
Natalia Mazurek
Born in Lublin. Currently lives in Lublin. Studied at John Paul II Catholic University of Lublin. Has a scholarship Logroño 2018 / 2019 at university Universidad de La Rioja
-
 Nadia Safia Chenouf
Nadia Safia Chenouf
Born in Algiers. Currently lives in Algiers. Studied at Université D'Alger I. Has a scholarship Logroño 2018 / 2019 at university Universidad de La Rioja
-
 Najiba El Ouardi
Najiba El Ouardi
Has a scholarship Logroño 2018 / 2019
-
 Sage Romo
Sage Romo
Born in Tecate. Currently lives in Ensenada. Studied at Universidad Autónoma de Baja California. Has a scholarship Logroño 2018 / 2019 at university Universidad de La Rioja
-
 Drake Allegrini
Drake Allegrini
Has a scholarship Logroño 2018 / 2019
-
 Francesco Flagiello
Francesco Flagiello
Born in Naples. Currently lives in Campobasso. Studied at Università degli Studi di Siena. Has a scholarship Logroño 2018 / 2019
-
 Mattia Pellati
Mattia Pellati
Has a scholarship Logroño 2018 / 2019
-
 Azucena Cambarao
Azucena Cambarao
Born in Córdoba. Currently lives in Córdoba. Studied at Universidad de Córdoba. Has a scholarship Logroño 2019 / 2020 at university Universidad de La Rioja
-
 Martina Sbrighi
Martina Sbrighi
Born in Cesena. Currently lives in Gambettola. Has a scholarship Logroño 2018 / 2019
-
 saioa uriarte
saioa uriarte
Has a scholarship Logroño 2019 / 2020
-
 Lucien Bangoura
Lucien Bangoura
Born in Vitoria. Currently lives in Logroño. Studied at Universidad Francisco de Vitoria. Has a scholarship Logroño 2018 / 2019 at university International University of La Rioja
-
 Natalia Gómez Vesga
Natalia Gómez Vesga
Has a scholarship Logroño 2018 / 2019
-
 Cristina Hidalgo Rodríguez
Cristina Hidalgo Rodríguez
Born in Salamanca. Currently lives in Logroño. Studied at Universidad Nacional de Educacion a Distancia. Has a scholarship Logroño 2018 / 2019 at university Universidad Nacional de Educacion a Distancia
-
 Clément Genovesi
Clément Genovesi
Has a scholarship Logroño 2019 / 2020 at university Universidad de La Rioja
-
 Alejandro Alonso Aguaza
Alejandro Alonso Aguaza
Born in Murcia. Currently lives in Murcia. Studied at Universidad de Murcia. Has a scholarship Logroño 2018 / 2019 at university Universidad de La Rioja